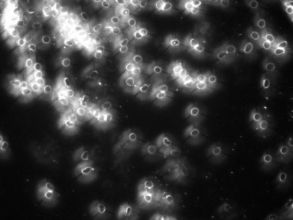
droog bloed analyse als scan voor verstoringen in het bloed

Health

TuiNa therapie
Voetreflex STER-therapie
De punten onder de voet, die ook wel meridianen worden genoemd, staan in verbinding met de energiebanen in het lichaam. Het zelfgenezingsproces in het lichaam wordt geactiveerd en regulerende invloeden ontstaan die genezing tot gevolg heeft.
De massage is geschikt voor jong en oud en is een behandelmethode voor klachten zoals: hoofdpijn, depressie, vermoeidheid, menstruatiepijn, verkoudheid, gespannen/onrustig zijn, slapeloosheid, pijnklachten en koude handen en voeten.
De voetreflexmassage kan ik ook bij je thuis geven.

Gua Sha

Gua Sha is een schraaptechniek, die vrijwel in alle oude culturen door artsen en de gewone bevolking werd toegepast. Het schrapen werd met verschillende instrumenten gedaan, zoals hoorn, koperen muntjes, porseleinen lepels en met jade steen. Het schrapen veroorzaakt rode vlekken of strepen. Hoe grotere stagnatie er zit, hoe donkerde de verkleuring is.
Gua Sha wordt gebruikt bij diverse problemen, zoals verkoudheid, hoofdpijn, nekpijn, rugpijn, spierpijn etc. Vroeger werd de kennis overgedragen van vader op zoon. Tot op heden wordt Gua Sha toegepast in de Aziatische culturen en sinds kort ook in Nederland.
Binnen de TCM (TuiNa Chinese Massage) neemt Gua Sha een belangrijke plaats in. Gua Sha betekent letterlijk: ‘de ziekte eruit schrapen’.
Reiki
Dit doe ik via de voeten en plekken waar extra energie nodig is. Het ontspant lichaam, geest en emoties.
Het zal jezelf en anderen in balans brengen.
De Reiki beginselen zijn richtlijnen en bieden ondersteuning in ieders ontwikkeling.
geen zorgen ❖
Roep vandaag geen woede
of boosheid op ❖
Eer je vader en moeder
je leermeesters en ouderen ❖
Leef oprecht ❖
Toon dankbaarheid aan
elk levend wezen ❖
Cupping

Cupping is een techniek om wind-koude uit te drijven, Oi/bloed stagnatie en pijn op te heffen. Dit gebeurt door potjes (glazen, bamboe, aardewerk, plastic) op de huid te plaatsen en in het potje een vacuüm te creëren. Dit vacuüm trekt de huid en spierlaag omhoog, waardoor er een betere doorbloeding en een betere lymfe circulatie ontstaat. Hierdoor worden de afvalstoffen beter afgevoerd en nieuw lymfevocht in omloop gebracht, waardoor weefsels beter gevoed worden en het immuunsysteem wordt versterkt. Bloed wordt gezuiverd, verstopping wordt naar boven getrokken, rode en witte bloedcellen worden aangemaakt en het verwijdert de verzuring. Stimuleert het zenuwstelsel, vooral op de rug, waardoor ook de verschillende organen worden gestimuleerd en zo beter worden aangestuurd. Deze stimulatie heeft een extra effect op langere termijn, het verbetert namelijk de weerstand.
Te gebruiken bij stagnatie van energie en bloed doorstroming, van het binnen dringen van virussen en bacteriën, kou, wind en vocht. Verkoudheden, astma, verteringsproblemen, huidproblemen, tennisarm, golfarm, achillespeesontsteking, slijmbeursontsteking, enz.
Magnesium
-
Stress
-
Reumatische aandoeningen
-
Spierpijn en kramp (o.a. restless legs)
-
Vermoeidheid en slapeloosheid
-
Huidaandoeningen (psoriasis, eczeem), jeuk en schilfers

Checklist Magnesiumtekort
-
Kramp:
-
Pijnlijke spieren & gewrichten:
-
Spanning of stress:
-
Slapeloosheid:
-
Weinig energie:
-
Hoofdpijn:
-
Huidklachten (bv. eczeem, psoriasis):
Healthcheck
Download hier de vragenlijst voor het intakegesprek
Detoxprogramma

WAAROM DETOXEN (ONTGIFTEN)?
Afvalstoffen in het lichaam kunnen leiden tot verstoringen van stofwisselingsprocessen, stijve spieren, ontstekingen, mentale spanningen, huidproblemen, haaruitval etc.
Door ontgiften(detoxen) blijft het lichaam vitaal en energiek. Korte detoxkuren, zoals sapvasten hebben vaak maar beperkt resultaat. Het lichaam heeft dan te weinig tijd om jarenlang opgebouwde toxines volledig af te voeren.
Dit detoxprogamma wordt rustig opgebouwd om eventuele blokkades in de ontgifting stap voor stap op te lossen.
Ook basische lig- of voetbaden komen in iedere stap terug. Hiermee wordt de huid en het lymfesysteem gereinigd. Veel toxines worden op deze manier uitgescheiden, zonder dat de nieren ermee belast worden. Gebruik je medicijnen of bent je onder behandeling bij een arts, vraag dan of dit ontgiftingsprogamma je reguliere behandeling nadelig kan beïnvloeden. Bij gebruik van pijnstillers, bloeddrukverlagers of andere medicijnen bv. dient er voorzichtig ontgift te worden met regelmatige controles.

SOORTEN TOXINES
Pijnbestrijding met acupunctuur
Pijn kan heel vervelend zijn en kan je leven beheersen. Daarnaast is pijn een natuurlijk signaal dat er iets mis is in je lichaam.
Bij acupunctuur wordt gekeken waar in het lichaam de energie niet of niet voldoende kan stromen. Hierdoor kunnen pijnklachten ontstaan en kunnen afvalstoffen zich ophopen in het lichaam. Bij acupunctuur wordt de pijn verminderd door met naalden die plekken aan te prikken, zodat blokkades worden opgeheven en de energie weer kan gaan stromen.
Ik werk volgens een protocol: ik kijk waar de pijn zit en welke meridiaan hierbij betrokken is. Van daaruit heb ik een aantal acupunctuurpunten die ik aan prik om op die plek in jouw lichaam zo veel mogelijk beweging te creëren. Door dit te realiseren wordt de blokkade opgeheven en zo ook de pijn. Met één of meerdere behandelingen kan dit gerealiseerd worden, afhankelijk van de soort klacht en hoe lang de klacht er al is.
Deze methode kan verlichting bieden bij klachten zoals: tennisarm, golfarm, nek, schouder, rug, beenklachten, enz.

Droog en Levend Bloed Analyse

Levend Bloed Analyse
Levend bloed analyse is heel geschikt voor het herkennen van stofwisselings- en immuunsystemen. Door middel van het afnemen van een paar druppeltjes bloed via een vingerprikje, kunnen we heel veel aan jouw bloed aflezen. Er wordt gewerkt met een preparaat, waarin de witte en rode bloedcellen uren lang actief kunnen blijven. Vandaar dat er wordt gesproken van levend bloed.

Droog Bloed Analyse

Kom je voor tweede analyse, dan kan je bij de tweede analyse kijken of je bloed verbeterd is door eventuele aanpassingen in je levensstijl of het gebruik van de aanbevolen supplementen.
Let wel! Levend en droog Bloed Analyse is een analyse en geen diagnose. Voor een diagnose dien je te allen tijde contact op te nemen met je huisarts of behandelend arts. Indien ik daar aanleiding toe zie, zal ik je adviseren om bij je arts langs te gaan.
Moxa behandeling
Moxa is een andere naam voor artemisia vulgaris of bijvoet kruid. Het word gebruikt om punten of delen van het lichaam te behandelen door aan te steken en boven de aangedane delen te bewegen. Het kruid geeft een weldadige infrarood straling waardoor de patiënt een rustgevende diepe warmte ervaart.
Moxa is heel goed te herkennen aan zijn geur. Het is een redelijk sterke geur en wordt regelmatig gelinkt met marihuana. Moxa is niet rookbaar, want het is een giftig kruid.
Eigenlijk is de warmte maar een bijproduct, de echte werking van moxa is dat de Oi (energie) en Yang (beweging) genereert. Moxa beïnvloed rode en witte bloedcellen en stimuleert de hormoonproductie waardoor er een betere bloedcirculatie ontstaat.

Indicaties:
- Bij moeheid/gebrek aan energie
- zwakte
- Slapeloosheid
- Chronische pijnen
- Littekens
- Reuma en artritis
- Snelle verdwijnen van blauwe plekken
- Beinvloed maag en darmen
- Versterkt de immuunsysteem
- Verbetert de circulatie van Oi (energie) en bloed
Contra indicaties:
- Niet bij koorts
- Te hoge bloeddruk
- Extreme vermoeidheid
- Niet onder de 12 jaar
Bij zwangerschap, behalve met stuitligging van het kind, kunnen we er mee draaien.


